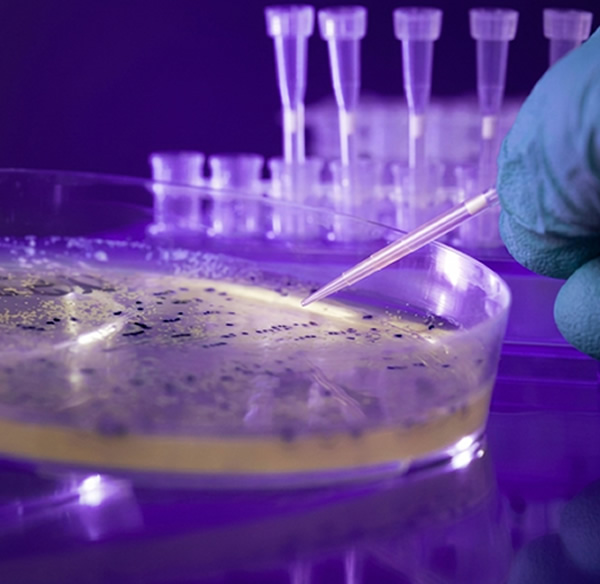
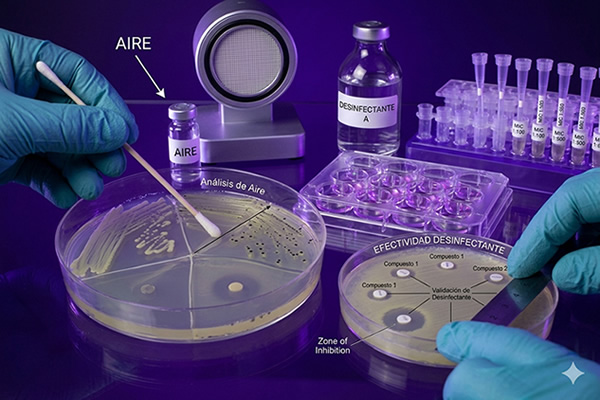

Recuento aeróbico total
Recuento anaeróbico total
Recuento de enterobacterias
Recuento de Lactobacillus
Coliformes totales
Coliformes fecales
Mohos y levaduras
Escherichia coli
Staphylococcus aureus
Salmonella spp.
Bacillus cereus
Enterobacteriaceae
Listeria monocytogenes
Escherichia coli 0157:H7
Yersinia spp.
Yersinia enterocolítica
Enterobacter sakazakii (Cronobacter)
Vibrio parahaemolyticus
Vibrio cholerae
Campylobacter spp.
Shigella spp.
Bacterias acido lácticas
Clostridium perfringes
Clostridium botulinum
Pseudomonas aeruginosa
Consulte por otros patógenos
Manos
Superficies
Empaques y envases
Ambiente en placa
Bebidas carbonatadas
Efectividad germicida en jabones y desinfectantes
Aire comprimido
Esterilidad comercial
Cosméticos
Ambiente e instrumentación hospitalaria
Estudio de vida útil en alimentos industriales